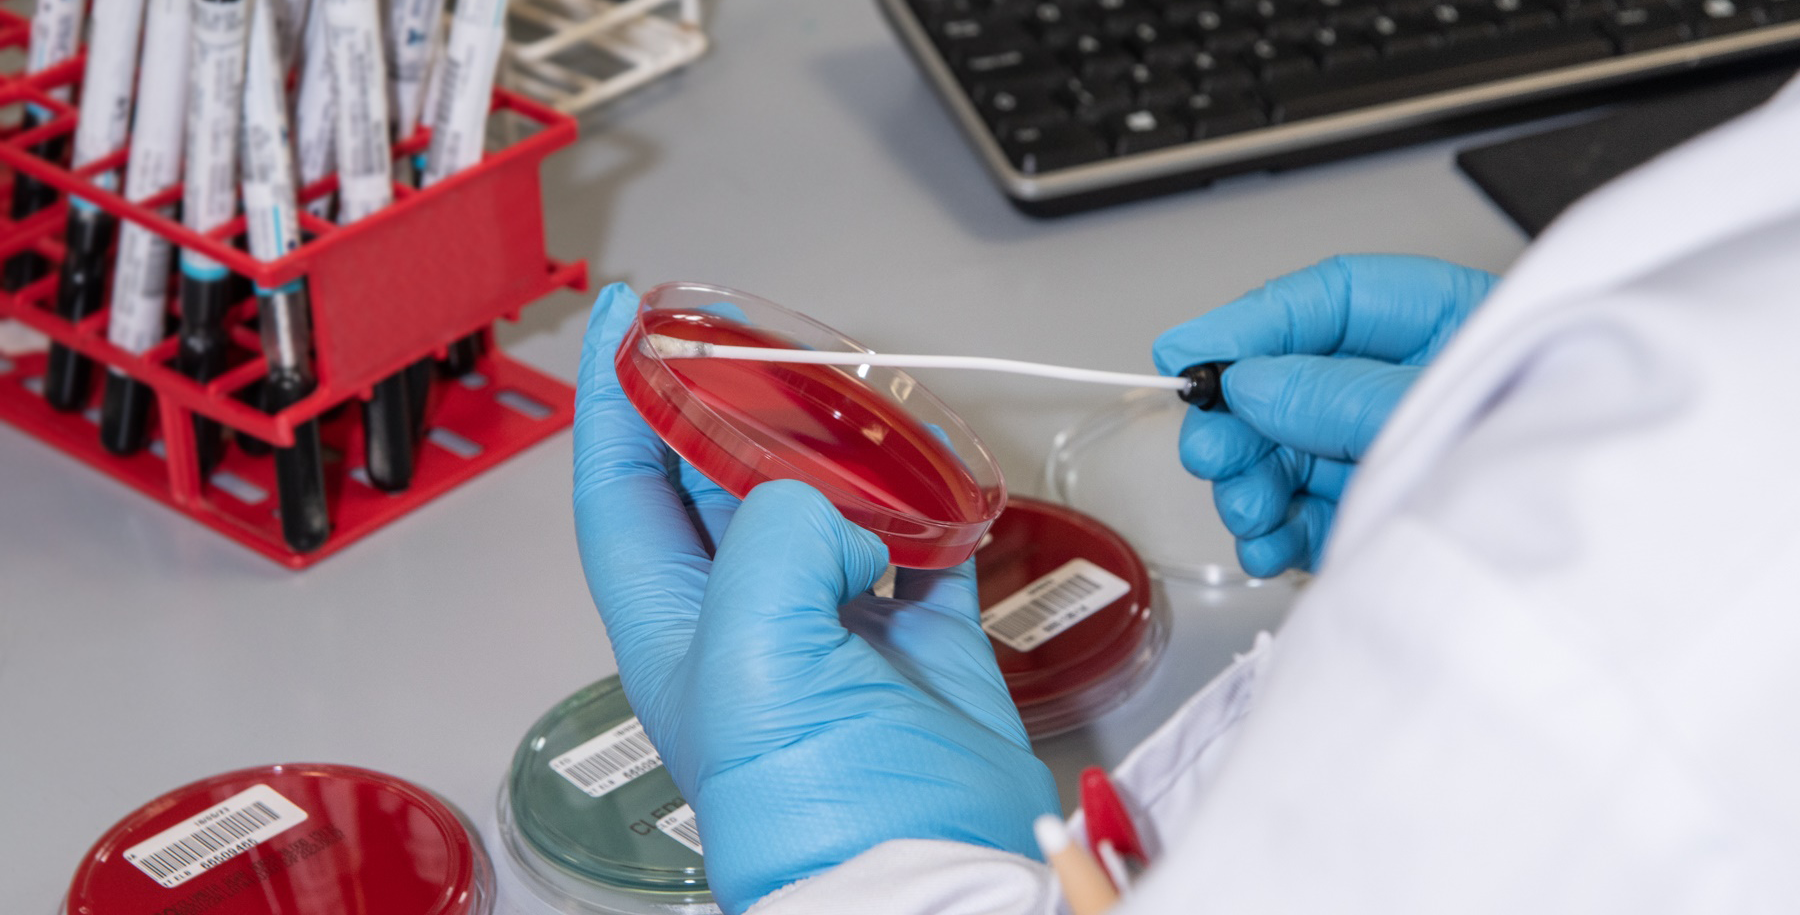

Microbiology
The Microbiology laboratory service at George Eliot Hospital and South Warwick Hospital is now at the single-site laboratory at University Hospital, as part of the Coventry and Warwickshire Pathology Services.
While the laboratory service is centralised, there is still a consultant service at each Trust. Trust clinicians and General Practitioners previously using the laboratory at an individual Trust are encouraged to maintain the same clinical links with the consultant microbiologists based at that Trust.
The Microbiology Laboratory is located on the fourth floor of the West Wing, University Hospital, Coventry. The following services are provided:
Bacteriology
Mycology
Parasitology
Routine Service
The Bacteriology laboratory is open between 0800 and 2100 7 days per week including bank holidays. The Virology laboratory is open between 0800 hours and 1800 hours and the Molecular laboratory between 0800 and 1700 from Monday to Friday for the examination of routine specimens. There are regular transport links between George Eliot Hospital and South Warwick Hospital to the UHCW laboratory 7 days a week.
On weekends and bank holiday only the more significant specimens, that cannot wait until the next working day will be processed. For urgent samples a member of the laboratory staff must be informed that such a specimen is being sent. The accompanying request forms must be marked 'urgent'
Microbiology should be telephoned on Ext 25426 to inform them of urgent specimens.
Emergency Service
During Laboratory hours
The service is initiated by the medical officer telephoning the laboratory to discuss nature of the specimen. Internal telephone number: Bacteriology 25426, Virology 25468. Personal contact is necessary and specimens and request forms must be marked "Emergency specimen". Specimens for departments other than Microbiology must be separately labelled. The labelled specimen and completed request form are then forwarded as follows (directly or through): -
Pathology Reception, UHCW
Phlebotomy/Pathology Reception, St Cross Hospital
George Eliot Hospital, Blood Sciences Reception, Pathology
South Warwick Hospital, Blood Sciences Reception, Pathology
Outside Laboratory hours
Medical advice is always available 24 hours a day 365 days of the year via the University Hospital switchboard (024 76964000).
A Biomedical Scientist (BMS) is available for processing specimens and can be contacted via the same number above. The on call BMS will advise on the most suitable specimen(s) and its (their) preservation during transport to the designated collection point. Please note ALL on-call specimens are processed at University Hospital, and are sent there.
Special points
- It is the responsibility of the clinician to contact the on call BMS to process specimens, required for the immediate management of the patient. Give details of any antibiotic therapy that is to be started.
- Non urgent specimens that have to be collected before antibiotic therapy is instituted, may be preserved by placing them in an appropriate transport medium (swabs), container with preservative (urine) and in a refrigerator until the laboratory is open.
Hyperimmune Immunoglobulins
The laboratory authorises the issuing of hyperimmune immunoglobulin for the prophylaxis of specific infections (Hepatitis B, Varicella Zoster) after prior discussion with medical virologist (or medical microbiologist after hours).
Clinical Advice
The medical staff, accessible on the numbers below, provide clinical advice covering all aspects of the service. In the event of a microbiologist not being directly available either leave a message with the secretary, or where required more urgently contact by long range bleep / mobile phone via University Hospital switchboard (024 76964000).
UHCW routine call times are 11.00-12.30, 15.00-16.00.
This does not affect GPs, urgent hospital calls and advice provided by medics.
Multidisciplinary Team (MDT) jointly run by Microbiology
|
MDT |
Day |
Time |
|
TB/Infectious Disease |
Monday |
12:30-13:30 |
|
Renal |
Tuesday |
09:30-10:30 |
|
Bone and Joint Infection Group (BIGCOW) |
Alternate Tuesdays |
1pm 3pm |
|
Haematology |
Thursday |
13:30-14:30 |
|
Infective Endocarditis |
Thursday |
10:00-11:00 |
|
Neurosurgery |
Friday |
10:30-13:00 |
Information required on request form
It is essential that all sections of the request form are completed.
The tests performed on specimens depend on the patient’s clinical details provided on the form; if these are incomplete then appropriate tests may fail to be performed. For example, Vibrio cholerae is not routinely examined for in stool specimens, the investigation being dependent on, for example, a relevant travel history.
Specimen collection
Specimens must be taken using steps to minimise contamination and delivered to microbiology as soon as possible. Specimen containers must be labelled with patient’s name, hospital number or date of birth and specimen type.
Specimen containers must be approved containers only
Staff should wash their hands before and after taking specimens and take appropriate safety precautions.
Swabs (see individual test library)
Bacteriology Turnaround Times
Turnaround time is the time from date of receipt into the laboratory to the issue of the final report. Microbiology aim to achieve the quoted turnaround time for 85% of samples received.
Turnaround time will be extended for samples received after 4.00pm (Mon-Fri), samples received on Saturdays, Sundays or Bank Holidays, samples requesting complex investigations or additional tests and samples which are referred to other laboratories for testing.
Final results are reported electronically by GP Link or to the electronic ward reporting system (CRRS/Review/ICE) as soon as they are available. Some preliminary results are also delivered electronically. Significant results, where early diagnosis would be beneficial to the management of the patient, are telephoned immediately by the Duty Microbiologist.
Further advice on sample collection and types of sample required is available elsewhere on this website or by contacting the laboratory.
Factors Affecting Results
The following are important considerations when submitting samples for bacteriological investigation:
Specimen collection: Samples and request forms should be labelled with sufficient information to allow identification of the patient and requester. Relevant clinical details should be provided. Unlabelled or mis-labelled samples may not be examined. Incomplete requester detail will result in no report being received. Incomplete request forms or incomplete clinical details may lead to inappropriate tests being performed.
Delay in transport: Samples for bacteriological investigation should be transported without delay to the laboratory. Delayed transport may affect the viability of pathogens and allow overgrowth of normal flora. Morphological appearance of cells may also be affected.
Transport medium: Swab samples for bacteriology should be sent in charcoal transport medium. Urines for bacterial culture (not TB) should be sent in a sterile universal container with boric acid (red top). Pus, aspirated fluids and urine for TB culture should be sent in a sterile universal container. Tissues and biopsies should be free from formalin. Use of dry swabs affects the recovery of fastidious organisms. Use of non-sterile containers can allow overgrowth of contaminating organisms. Use of formalin affects the viability of bacteria.
Temperature extremes: Samples for bacteriology should be kept cool if not transported immediately to the laboratory. High temperature can lead to overgrowth of normal flora and may kill the target organism. Low temperature can affect recovery of some susceptible organisms.
Measurement of uncertainty Measurement of uncertainty (MU) information is available for users on request from the laboratory.
Additional tests
Additional requests for bacteriology specimens already received are not permitted unless specifically agreed with the Microbiology clinical staff
Medico legal cases
For medico legal cases i.e.: rape, sexual abuse etc, specific protocols have to be followed in order for any evidence to be accepted as genuine. In these circumstances please discuss with either GUM consultant, or consultant microbiologist before submitting any specimens.
A chain of evidence must be used for these samples.
Trichomonas vaginalis
T vaginalis is a fragile organism and may not survive transportation on a swab
T vaginalis culture is not routinely performed in the laboratory
Sputum
Sputum samples for C&S
These are collected by expectoration directly into screw capped universal containers. A good quality specimen is essential i.e. purulent material, salivary samples may be rejected for routine culture. BAL specimens should be clearly marked as such.
Sputum for TB
Three consecutive early morning samples should be sent to the laboratory together with a request form indicating that processing for TB is required
Blood Culture
A set of two 'BacT/Alert' bottles (aerobic/anaerobic) is required for adults and a single bottle for paediatric. When investigating Pyrexia of Unknown Origin or suspected endocarditis, three sets should be taken over a period of time. For example in the case of “sub-acute endocarditis”, three sets should be collected over several hours before a suitable antibiotic regime is started. For suspected line infections a peripheral culture as well as line culture is recommended (ensure bottle(s) and form are labelled clearly line or peripheral culture). Any relevant clinical details such as foreign travel should be stated.
How to collect blood for culture
The blood should be collected before antibiotic therapy is begun and preferably while the patient has a rising temperature.
Strict asepsis must be observed. Remove plastic flip-top from each culture bottle and disinfect with an alcohol pad. Treat the skin with alcohol. Allow to dry for at least one minute, collect up to 20mL of blood by venepuncture. Change needles and dispose the needle into Sharpsafe container. Inject up to 10mL into each bottle, inoculating the anaerobic bottle first. Mix gently and label all bottles with the patient's details. Transfer both bar-code strips from the bottles to the front of the request form. DO NOT COVER the bar-code on the bottle with the patient label.
Tuberculosis
In cases where “miliary” tuberculosis is suspected, two sodium citrate tubes (light blue) can be collected for liquid TB culture.
Laboratory Procedure
Blood cultures are examined visually on arrival and thereafter monitored constantly by machine. If growth is detected, Gram films and subcultures are done to identify the organism and significant results are reported by telephone.
Urine
Mid-stream, clean-catch specimens are obtained to avoid contamination. For some patients it may be necessary to collect a ‘catheter specimen’ or ‘bag urine’ and this must be clearly stated on the request form.
- Collection of Mid-stream specimens of urine
The genitalia should be washed thoroughly with soap and water and dried. The labia should be separated or the foreskin drawn back, far enough to expose the urethral opening.
The first urine passed should NOT be collected. The middle part of the urine stream should be collected in a sterile container. This should then be placed in a sterile universal container containing boric acid (red top) and filled to the level indicated. Screw cap on tightly and mix with boric acid powder thoroughly with the urine. Boric acid stabilises the bacterial population until the specimen is processed in the laboratory, but the specimen MUST BE SENT TO THE LABORATORY WITHOUT DELAY.
When only a small amount of urine can be obtained, place in a sterile universal container without boric acid. Again refer to the laboratory immediately, or refrigerate specimen until possible.
Urine which are not received in white top universal will be rejected unless they meet any of the following criteria:
- Small volume (<5ml) urine samples in any patient cohort.
- Nephrostomy, urostomy, cystoscopy, ileal conduit samples
- Any child <5yrs old
- Schistosoma investigation
- Supra-pubic aspirate
- Samples for TB investigation
Please see Urine collection guide:
Urine samples are often collected in attempts to microbiologically confirm the diagnosis of a lower or upper urinary tract infection. There is little value in performing a dipstick on urine samples in the > 65 years age group due to a high false-positive rate caused by the presence of non-pathogenic bacteria. Therefore, we have to rely on culture to produce a result.
 When to send urine samples for microbiological culture
When to send urine samples for microbiological culture
Signs and symptoms of UTI: Dysuria, frequency, urgency, suprapubic pain, polyuria.
Signs and symptoms of upper UTI (UUTI): As per UTI, plus loin pain, flank tenderness, fever, other manifestations of systemic inflammatory response.
How to collect urine samples for mycobacterial culture1
- Send mid-stream urine samples if possible, and prior to commencing antimicrobial therapy.
- Fill to the fill line wherever possible
- The container MUST BE LABELLED with the patient’s details and placed in a clear plastic bag accompanied by a completed blue microbiology request form then delivered to the laboratory.
DO NOT USE DIPSTICK IN THE DIAGNOSIS OF UTI ION OLDER PEOPLE >65 YEARS OR CATHETERISED PATIENTS.
Completing the request form
- Clinical details MUST state:
- Symptoms with date of onset
- Any antimicrobial therapy
- Request for microscopy, culture & sensitivity
- Plus (if required):
- Chlamydia/gonorrhoea
- Acid fast bacilli/TB- send 3 consecutive early morning urine Samples in white topped containers only
- Schistosomiasis- send midday urine sample in a white-topped Universal tube
Reference
1/PHE (2019). Investigation of urine. https://assets.publishing.service.gov.uk/government/uploads/system/uploads/attachment_data/file/770688/B_41i8.7.pdf
2/ PHE (2017). Investigation of specimens other than blood for parasites https://assets.publishing.service.gov.uk/government/uploads/system/uploads/attachment_data/file/622944/B_31i5.1.pdf
b. Catheter specimens of urine
In most circumstances, such specimens should only be taken when the patient is systemically unwell, e.g. pyrexial. Urine should be collected directly via the catheter tubing via the aspiration port. Swab port with 70% alcohol swab allow to dry, and then aspirate urine using needle and syringe (taking care to avoid sharps injuries). DO NOT collect urine from the catheter bag.
c. Culture of urine for Mycobacterium tuberculosis
The first 30ml or so of the first morning specimen of urine passed by the patient should be obtained by a clean catch technique on each of three successive days. The urine should be transferred to a plain sterile screw capped sterile universal container (DO NOT USE BORIC ACID CONTAINER), filling it to the shoulder. The lid should be screwed on tightly. The request form and specimen should be clearly marked according to the day of collection; e.g. EMSU 1st day for TB culture.
Faeces
Plastic disposable screw capped containers with enclosed spoon are used. Two spoonfuls will suffice for most microbiological investigations, but don’t fill more than 1/3rd. Special care should be taken with fluid stools to ensure that the container is securely closed. Rectal swabs should only be sent for multiresistant/ CPE organism screen as a negative routine culture result is not as reliable.
a. Faecal culture
Specimens from the community and all “admissions” units are routinely examined for Salmonella, Shigella, Campylobacter and Verotoxogenic E coli 0157. Further investigations will be guided by clinical details. All specimens from adults are tested for Clostridium difficile toxin (see below).
b. Parasitology investigations
Specimens are not routinely examined for parasites. Where indicated please request parasitology on the form and give supporting clinical details. As excretion of parasites may be intermittent three separate stool specimens may be required and it is essential that they are collected on different days. If amoebic dysentery suspected, a “hot stool” specimen is required. For the detection of S. haematobium;
A complete urine sample collected between 10am – 2pm should be submitted.
c. Threadworm investigation
An anal swab in saline is now preferred over a sellotape slide. The anus should be swabbed, and the swab then placed in a sterile universal container half filled with normal saline.
d. Clostridium difficile
Clostridium difficile may produce a wide spectrum of diarrhoeal illness through to life threatening pseudomembranous colitis. Infection is almost always associated with antibiotic use (a significant percentage of cases arise after stopping the antibiotics). C. difficile is a predominantly hospital associated organism, but with shorter hospital stays more cases are likely to arise in the community. All stools from adult patients are routinely tested for the toxin of Clostridium difficile (CDT).
Only samples which take the shape of the container will be tested for C-diff in line with national guidance.
e. Viral diarrhoea
For investigation of viral causes of gastroenteritis in children under 5, (Rotavirus/Adenovirus), submit a stool specimen as described above requesting viral investigation.
f. CPE/CRO screening
Rectal swab or faeces required for Molecular method. This is for GEH and SWUFT only. Please see details in Virology section.
Fungal Infections of the Body Surface
These are diagnosed by direct microscopy and culture, the latter being more sensitive.
Skin scrapings, nail parings or depilated hairs should be sent in a small sheet of clean paper, preferably black, folded three times, marked with the patient's details, and attached to the request form. If it has to be sent from outside the hospital, the form and attached packet of material should be put in an envelope. For thrush, throat swabs may be used as for Bacteriology.
Systemic Fungal infections
Please contact the microbiologist for advice on diagnosis and treatment.
Antibiotic dosing / levels (please see the UHCW Trust intranet)
NB. All antibiotics are now analysed by the Biochemistry department. Please use biochemistry request forms, clearly marking the antibiotic assay(s) required. Please also use the standard biochemistry clotted tube and if other biochemistry tests are required, a separate sample tube is not required.